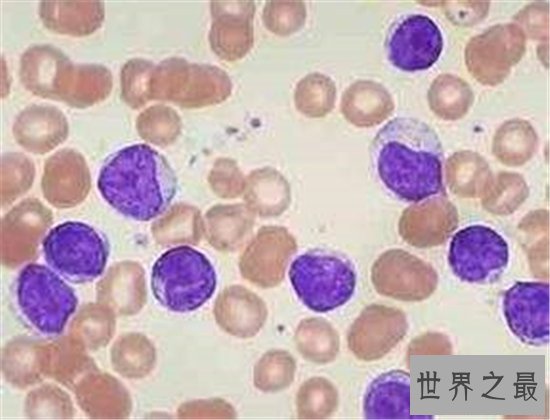
十大致命类型的癌症,都是很难治愈的癌症!

十大超可爱的海蛞蝓排行榜,简直都要萌化你的心了
十大超可爱的海蛞蝓排行榜,简直都要萌化你的心了 世界上有很多种海蛞蝓,而且大多数都长相可爱,形态奇特,又被人们成为海燕,小编为大家整理了十大超可爱的海蛞蝓排行榜,简...
十大致命类型的癌症,都是很难治愈的癌症!
癌细胞,是每个人体内或多或少都会存在的一种东西,有的人体内癌细胞较少,身体健康不会受到威胁,而有的人体内癌细胞较多,最终转换成了一种癌症,严重会导致人的死亡。下面,我们一起看看十大致命类型的癌症是哪些吧!
十大致命类型的癌症:肺癌、乳癌、肝内胆管细胞癌、前列腺癌、急性淋巴细胞白血病、结肠直肠癌、非霍奇金淋巴瘤、肝细胞性肝癌、胰腺癌、神经系统和脑癌
十大致命类型的癌症1、肺癌

吸烟有害健康这句话真的不是开玩笑的,很多时候吸烟会造成许多让人困扰的事情,肺癌就是其中之一。它是吸烟人士很容易感染的一种疾病,当然也包括经常吸二手烟的人群,出现的病状有:胸口阵痛、咳嗽出血、呼吸困难。
2、乳癌

现今社会有很多女性感染乳癌,非常恐怖,病情恶化时还需要切割身体的乳房。这种癌症并不仅仅局限于家庭遗传,有些大多患病者都是因为生活中太过压抑,导致情绪化,而这种情绪又长时间挤压在体内,严重时会导致死亡。
3、肝内胆管细胞癌

肝内胆管细胞癌与别的癌症不同,它是一种慢性疾病。这种癌症隐藏在肝脏内壁,影响着肝脏里的消化功能,对于人们身体的伤害很大,如果不小心处理的话有可能会造成生命的危险,也被人们排列在十大致命类型的癌症里。
4、前列腺癌

前列腺癌是我们现实生活中很常见的一种癌症,主要患病人群集中在非洲裔的美国人里面。而这种病症的出现主要是由于长期的不合理饮食,例如长时间吃高热量的乳类、肉食,不吃维生素的绿色食品都很容易患这一疾病。
5、急性淋巴细胞白血病
说起致命类型的癌症,我想必须要注意的就是急性淋巴细胞白血病。这是一种经常发生在小孩和老人身上的病症,据调查显示,平均一年有一千以上的人死于这种病,主要的疾病状况是胸口疼痛、贫血等,非常危险的癌症之一。
6、结肠直肠癌

很多感染结肠直肠癌的人在患病初期都没有任何感觉,因为这是一种慢性疾病。这种疾病患者体内通常都会长着恶性肿瘤,肿瘤的生长也会直接影响病情的发展,一般都会出现便秘甚至便血的现象,长期不治疗的话有可能会致命。
7、非霍奇金淋巴瘤

淋巴病非常可怕,非霍奇金淋巴瘤就是淋巴病的一种。这种疾病的治疗费用很高,但是成功率极低,如果发现的早的话也许可以维持身体正常代谢,发现的晚的话严重时将会导致性命受到致命伤害,是十大致命类型的癌症之一。
8、肝细胞性肝癌

肝细胞性肝癌比别的疾病要棘手一些,是一种会致命的疾病。这种病在医学上是一种慢性疾病,只能采用肝脏移植或者动手术的方式进行治愈,不过要找到一颗适合自己的肝脏要花费的资金和精力也是很多的,所以非常难治愈。
9、胰腺癌

胰腺癌是近几年来很多人容易出现的疾病,这种癌症的风险超级大,不仅治愈的可能性低,还需要高昂费用。它的癌细胞隐藏在腹部,影响着我们的胰腺功能的作用,经常会出现疼痛的情况,如果没有药物的控制将会缩短寿命。
10、神经系统和脑癌

神经系统和脑癌虽然较多集中在小孩和老人身上,但也是所有年龄段都有注意的一种癌症。它非常危险,对人体伤害是很大的,通常都会出现非常爱睡觉的病症,这种癌症几乎没有痊愈的治疗方案,晚期患者的病情更是难控制。
十大超可爱的海蛞蝓排行榜,简直都要萌化你的心了 世界上有很多种海蛞蝓,而且大多数都长相可爱,形态奇特,又被人们成为海燕,小编为大家整理了十大超可爱的海蛞蝓排行榜,简...
跑得快的动物排行榜,猎豹竟然不是第一 在自然界为了活命,速度非常重要。无论是逃避天敌还是捕捉猎物,高速都会让动物们抢得先机。可以说,跑的快,活下去的机会会更大些。今...
中国十大重要节日英文(中国重要节日英语) 本文目录一览: 1、中国的传统节日有那些,请用英语回答2、各种中国传统节日的英文介绍3、中国传统节日英文版4、中国的节日有哪些?用...
中国十大极端履带车(全国最大的履带车厂家) 本文目录一览: 1、港口牵引车哪些品牌好?2、中国最大的车能吊多少吨3、中国对外出售的坦克装甲车都有什么4、坦克及履带式装甲车...
中国古代十大名楼,最熟悉的黄鹤楼位于榜单榜首! 中国历史博大精深,作为一个中国人都知道中国可以说是命途多舛的国家,但是作为四大文明古国之一的中国拥有悠久的历史文化瑰...
世界十大知名散粉品牌(前10排名散粉) 本文目录一览: 1、散粉哪个牌子好用推荐2、10款超好用的大牌散粉3、小红书散粉排行榜前十名4、散粉哪个牌子好?5、散粉排行榜前十名 散粉哪...
世界上最小的鸟,吸蜜蜂鸟体长仅3厘米(和硬币一样重) 说到世界上最小的鸟是哪个,我相信大多数人都会反应过来是麻雀,因为有一句话是这么的,麻雀虽小五脏俱全,这足以说明...
中国邮轮十大客源地(邮轮客源地集中在哪些地区) 本文目录一览: 1、中国邮轮母港有哪几个2、中国邮轮港口一共多少个,分别是哪些,要最新的谢谢3、.中国南极探险邮轮的客源主...
中国有地铁的城市排名,你的家乡通地铁了吗? 说到地铁,是目前全世界最为火爆的交通工具。地铁也是很便利的一项交通方式,现在技术非常的发达,我们国家也有越来越多的城市安...
中国十大留学机构2022(全国前十留学机构) 本文目录一览: 1、北京留学中介十大排名榜2、中国10大留学机构排名谁有?3、留学机构排行4、全国留学机构十大排名 北京留学中介十大排...
我的世界十大恐怖事件,老玩家都不知道的事 我的世界大家应该都知道这个游戏吧,咋一看就是一个粗糙的像素游戏,但是对于大神来说,这可真是大展身手的游戏,我的世界附魔也很...
万圣节恐怖电影TOP10,不能错过的十大经典电影! 万圣节是一个充满鬼怪的节日,很多人都喜欢在那天把自己打扮得像可怕的鬼一样,认为这是对节日的问候。而到了万圣节,我们最喜...
中国十大黑帮老大,中国十大黑帮老大各个都非常有钱。 世界上,每个人每分每秒都在扮演着不同的角色,每个人都有自己的性格和风格。在中国,各个地方都分散着不同的黑帮,他们...
中国黄金十大品牌(中国黄金十大品牌价格) 本文目录一览: 1、中国十大黄金品牌是哪些?2、中国黄金十大名牌排名3、十大黄金品牌排行榜 中国十大黄金品牌是哪些? 我们常见的品...
解放战争三大战役顺序,平津战役为内战画上句号 在说三大战役顺序之前,我先来科普下,解放战争三大战役是什么意思,在结束对外战争之后,国军一直针对共军,而共军也奋起反攻...
董鄂妃是顺治唯一的挚爱?孝庄太后憎恨董鄂妃为何不废其皇后 很多熟悉清朝 历史 的人们,都不由得被顺治帝和董鄂妃的爱情所打动。在不少人眼中,顺治帝和董鄂妃之间轰轰烈烈的...
床上戏最激烈的电视剧,滚床单只是初级选手! 床上戏,是现今很多电视剧中普遍存在的一个现象。也许爱情擦出火花会有适当的接吻、拥抱,但是有些电视剧就有点过分了,动不动就...
世界十大历史企业排名(世界十大历史企业排名榜) 本文目录一览: 1、全球知名的百年品牌或企业有哪些?2、1995年世界500强企业前十名3、全球市值前十大公司美国占了8个,大家怎么看...
上海十大最乱学校,上海滩名副其实的十大流氓学校 在我们普通人的认知中,上海的经济十分的发达,因此上海的教育也十分的先进,但是在教育先进的地方也会有不听话的学生,不听...
中国十大与世隔绝酒店(与世隔绝的旅游地方) 本文目录一览: 1、中国十大顶级酒店排名2、求中国十大顶级酒店排名,哪些比较值得入住?3、中国十大酒店集团分别是什么?4、中国十大...
中国十大食品车(中国食品十强) 本文目录一览: 1、传统美食有什么?2、十大特色美食小吃有哪些3、最古老的中华传统美食有哪些?4、韩式辣酱、辣椒酱、辣椒制品。品质品牌中国十...
无人机十大品牌排行榜,无人机哪个牌子好? 在这个科技发展越来越盛兴的时代,在各大不管是演出现场又或者是举行什么大型活动的时候,都少不了一件东西的存在,那就是无人机,...
中国十大防撞门厂(全国最好的防撞系统厂家) 本文目录一览: 1、会议室旋转门价格厂家介绍2、中国系统门窗十大名牌排名是怎么样的?3、工业厂房门生产厂家4、不锈钢防撞门哪家好...
世界污染最严重的河流,幼发拉底河再登榜首! 当今世界,环境污染问题一直是世界都关注的问题,而河流是哺育众多生物的重要源泉之一,在水污染问题现在越来越严重的情况下,我...